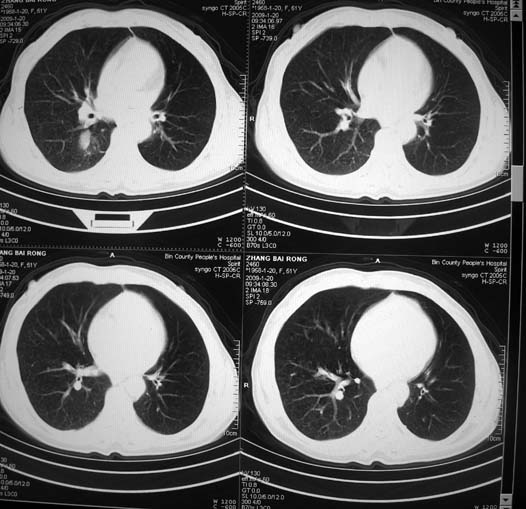

以下是引用zsl6918在2009-1-20 17:30:00的发言:[br]支持右肺下叶背段周围型肺癌,隆突下淋巴结肿大
以下是引用宇宙ct在2009-1-20 16:28:00的发言:[br]周围性肺癌\\纵隔淋巴转移
以下是引用sos.la在2009-1-20 18:01:00的发言:[br]实质性密度均匀肿块.边界清晰,浅分叶.无明显毛刺征,离胸膜近却无胸膜凹陷征,发生在段及段以下支气管,病灶直径远远超过此位置支气管管径而无阻塞征象,7#淋巴结肿大,病理是小细胞未分化癌(局限期)可能性最大.
| 欢迎光临 医影在线 (http://bbs.radida.com/bbs/) | Powered by Discuz! X3.2 |